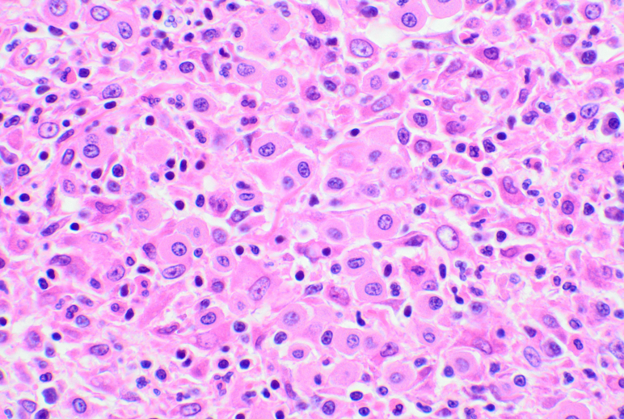

このコンテンツは獣医療従事者向けの内容です。
猫の肥満細胞腫(MCT)は、皮膚型と内臓型を合わせて猫の全腫瘍の約15%、皮膚型は皮膚腫瘍の約20%を占めるというメジャーな腫瘍です。にもかかわらず、犬のMCTと比較してあまり議論されることがないように思います。猫の皮膚肥満細胞腫(cMCT)はその多くが良性の挙動をとることから、議論の余地が少ないからかもしれません。先生方も経験上、猫の皮膚腫瘤を提出して「肥満細胞腫」と診断された場合、その多くは予後にあまり問題はないとお考えかと思います。
では実際のところ、悪性の挙動を示す猫のcMCTはどの程度存在するのでしょうか?そこで今回は、猫のcMCTの組織型およびグレード分類、KIT遺伝子の変異とメシル酸イマチニブに対する治療有効性との関連に加えて、弊社で診断した猫のcMCTのデータについてお話させていただこうと思います。
猫のcMCTは、細胞の特徴によって高分化型(図1)、非定型(または組織球型)(図2)、多形型(図3)、に分類されます。非定形型あるいは多形型のものは一見腫瘍細胞に異型性があるようですが、組織型と予後に有意な関連は今のところ報告されていません。そのため、病理組織学的に高分化型であっても必ずしも予後が良いとは限らず、低分化型のMCTであっても必ずしも予後が悪いわけではないという点に注意が必要です。また経験上、猫のcMCTでは、犬と比較して好酸球の浸潤に乏しく、病巣内に小型リンパ球の集簇巣がみられる場合が多いようです。

図1 高分化型
図2 非定型(組織球型)

図3 多形型
では、猫のcMCTを予後と関連したグレード分類することは可能なのでしょうか。2019年には、 Sabattini らにより高悪性度、低悪性度の2段階の組織学的分類が提唱されています(図4)*1。すなわち、核分裂像が強拡大10視野当たり5個以上認められ、かつ以下の3項目のうち2項目に当てはまれば高悪性度に分類されるというものです。
- 腫瘍の直径が1.5cmより大きい
- 不整な核
- 核クロマチンの凝集
図4 猫の皮膚肥満脂肪腫の組織学的グレード分類
Sabattiniらの報告によると、高悪性度に分類されたcMCTの全生存期間中央値は349日であり、低悪性度の場合は8年を超えて未到達でした。
この分類方法は組織学的なものであり、現在のところ猫のcMCTの細胞診によるグレード分類は行われていません。
過去半年間に弊社で診断された猫のcMCT、約400例のデータをご紹介します。
発生部位に関しては、体幹部と頭部で全体の60%を超え、特に頭部では耳介に多く発生していました(図5)。犬では体幹部と四肢での発生が多く、好発部位に違いがみられました。
発生年齢の中央値は9歳で、最も発生頻度の高い年齢は4歳,7歳で、4歳以下での発生が20.3%に上ることがわかりました(図6)。弊社における犬のcMCTのデータでは発生の中央値が10歳、最も発生頻度の高い年齢は11歳、4歳以下での発生が12.3%であることと比較して、猫ではより若齢での発生が多いことがわかります。
高悪性度に分類されたcMCTは423件中9件(2.1%)で、最も若齢での発生が7歳でした。このことから、必ずではないものの、7歳未満のcMCTについては低悪性度の可能性が高いと考えてよいかもしれません。

図5 発生部位分布(n=393)
図6 発生年齢分布(n=423)
近年、犬および猫のMCTにおいては、メシル酸イマチニブをはじめとするチロシンキナーゼ阻害剤(TKI:Tyrosine kinase inhibitor)を治療薬として選択するためのc-kit遺伝子検査が一般的になっています。猫のcMCTでは、主にKIT遺伝子のエクソン8と9の変異が知られており、変異症例ではKitタンパク質が活性化することにより腫瘍化が引き起こされます。イマチニブは、このシグナル伝達を阻害することにより増殖を抑制する分子標的薬です。特にエクソン8の変異に対して高い奏効率が示されており、変異が検出されたMCTにおいてはイマチニブの効果が期待されます。しかし、変異が認められていても耐性機構の存在により効果が認められない症例も存在することに注意が必要です。また、他の変異については少数の臨床例あるいは細胞レベルでの効果が示されています。さらに、変異が検出されなかった場合でもイマチニブの効果を示す症例が報告されています。
このように、猫のMCTにおけるイマチニブの効果予測についてはいまだあいまいな点が多く、さらなる症例の集積が必要と考えられます。
また、猫ではしばしば「色素性蕁麻疹様疾患/丘疹状肥満細胞症」という肥満細胞の増殖性疾患がみられます。本疾患は肥満細胞の浸潤が皮膚に限局して認められる肥満細胞症の一形態であり、自然退縮あるいは持続的な慢性皮膚炎へと移行する非腫瘍性疾患です。一般的に2.5歳齢以下の若齢猫に、多発性の丘疹病変としてみられます(図7)*2。遺伝的要因が疑われており、スフィンクス、デボンレックス、ヒマラヤン、シャムなどで報告がありますが、弊社ではロシアンブルーや日本猫においても本疾患を疑う症例が確認されています。このような病変は、組織像のみでは初期のcMCTとの鑑別が難しく、診断には多発性か否か、年齢、猫種などの臨床情報が重要になってきます。そのため、細胞診等により肥満細胞の増殖性疾患が疑われる場合には、臨床情報をなるべく詳細にご記載いたければと思います。

図7 色素性蕁麻疹様疾患/丘疹状肥満細胞症の丘疹病変(*2からの引用)
*1 Grading Cutaneous Mast Cell Tumors in Cats, Silvia Sabattini, Giuliano Bettini, Vet Pathol. 2019 Jan;56(1):43-49
*2 Feline maculopapular cutaneous mastocytosis: a retrospective study of 13 cases and proposal for a new classification, J Feline Med Surg. 2019 Apr;21(4):394-404.
【執筆:富士フイルムVETシステムズ 診断医 鄭 明奈】
